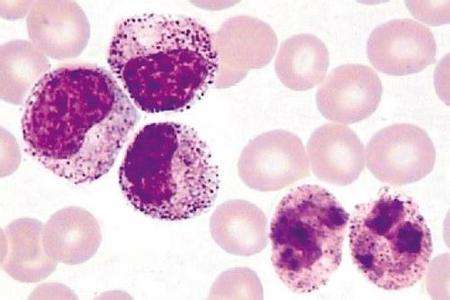

| 协议号 | 母亲姓名 | 脐血编号 |
|---|---|---|
| {{item.ProtocolId}} | {{item.CustName}} | {{item.StorageId}} |
时间:2017-08-06
“儿童白血病之王”幼年型粒单核细胞白血病(JMML)被攻克!
新快报记者于8月4日从南方医科大学南方医院了解到,该院儿科主任李春富带领的团队首创去甲基化联合父母半相合骨髓与非亲缘脐血双移植治疗法,目前治疗的14个病例中,13例病人存活并无中度以上并发症,在最长达39个月的随访时间内,无一例复发。

李春富介绍,幼年型粒单核细胞白血病素称“儿童白血病之王”,发病率只占儿童白血病的2%左右,但平均发病年龄只有2岁,病死率高,长期生存率不到10%。目前针对该病的最佳治疗方案是异基因造血干细胞移植(HCT),但治疗后复发率高达50%。因疗效差、花费巨大,家长往往选择放弃。
“新技术疗效的改善归功于对高甲基化在JMML中致病作用的认识和去甲基化药物在移植前后的应用,以及HCT技术的改进。”李春富称,研究表明,JMML病人通常甲基化水平很高,抑癌基因甲基化后作用丧失,癌细胞生长加速;相反抑癌基因去甲基化后作用恢复,癌细胞抑制。
经过研究,李春富团队发现,一方面,在移植前使用地西他滨降低肿瘤负荷有利于植入,在移植后再次使用地西他滨能够克服癌细胞免疫逃逸,降低复发。另一方面,李春富团队首创父母HCT和非亲缘脐血互补性移植,在父母半相合骨髓移植后的第六天植入非血缘脐血,改善了植入和增强了抗白血病效果。“父母半相合骨髓和非血缘脐血可以起到一个互补的作用,适者生存。”
2014年后,采用去甲基化治疗联合HCT的14位移植患者都输注了父母半相合骨髓和非血缘脐带血,最终一半以上的患者是脐带血成功植入,剩下的病人是父母半相合骨髓植入。迄今,共治疗14例JMML病童,最长随访时间39个月,无一例复发,13例病人目前存活并无中度以上并发症。
研究表明脐血有不低于骨髓的抗肿瘤效应,加上脐血库的资源弥补了骨髓库的不足,可以做多次配型,从中选择有更强抗肿瘤效果的脐血进行移植。据介绍,在JMML治疗上取得的经验也有益于其他白血病的治疗。
(来源:http://epaper.xkb.com.cn/view/1082922)